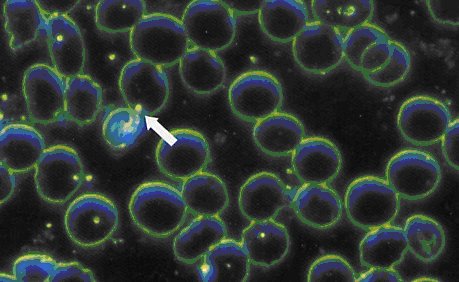
protits

Summarized by Walter

 This article attempts to simplify the differences between two systems of medicine, one based on Pasteur's germ theory [ monomorphism ] and the other on Bechamp’s cellular theory [ pleomorphism
]. The germ theory believes in specific, pre-existing germs outside the human body causing diseases while the cellular theory believes that diseases originate inside the
human body from tiny organisms that never die, can change form and cause diseases.
The two different theories are the basis for two different systems of medical
practice. This article takes a special look at pleomorphism.
This article attempts to simplify the differences between two systems of medicine, one based on Pasteur's germ theory [ monomorphism ] and the other on Bechamp’s cellular theory [ pleomorphism
]. The germ theory believes in specific, pre-existing germs outside the human body causing diseases while the cellular theory believes that diseases originate inside the
human body from tiny organisms that never die, can change form and cause diseases.
The two different theories are the basis for two different systems of medical
practice. This article takes a special look at pleomorphism.
|
The Disease Paradigm "One school of thought (modern medicine and the monomorphic perspective) says most disease is caused by germs or some form of static, disease-causing microbe (the germ theory). In order to get well, you should KILL the germs. KILL the microbes. KILL whatever is making you sick. Drugs, antibiotics, chemotherapy, radiation, surgery. The other school of thought (which encompasses most other forms of the healing arts unrelated to mainstream medicine) says most disease is caused by some unbalance in the body. The unbalance occurs in some nutritional, electrical, structural, toxicological or biological equation. In order to get well, you need to re-establish balance in your body by working with your body, not against it." Cowan: Pleomorphism |

 Bechamp's cellular theory is a revived challenge to how Western medicine is being practiced. Will medicine be turned upside down?
Bechamp's cellular theory is a revived challenge to how Western medicine is being practiced. Will medicine be turned upside down?
Background Medical Practice:
The practice of Western medicine today stems from belief in the germ theory and the Flexnir Report published in 1910. Wiki: Flexenir Report [ The Flexnir Report made recommendations, based on the germ theory, to improve the quality of medical education, and how medicine was to be practiced. ] The medical belief system has changed very little since then. Yes, we have had some wonderful advancements in public health, surgery and drug therapy. Despite all the self praise of the medical establishment, little progress has been made to bring chronic degenerative diseases like cancer and heart disease under control.
The practice of today’s medicine is based on the germ disease theory of Louis Pasteur that is almost 150 years old! Pasture a fraud | History of medical practice Pasture postulated that specific germs cause specific diseases. The Dream and Lie of Louis Pasteur Kill the germ and you control the disease. Well, it has NOT worked very well! The American health care system, in spite of President Obama's efforts of reform, is and will be in continuing trouble. US health care in crisis | Drug monopoly
Pasteur’s theory was based in the believe of monomorphism. One germ for a specific disease. But back in Pasteur’s day, this notion had been challenged by Bechamp and Professor Claude Bernard and their theory of Pleomorphism Cowan: Pleomorphism that cells, and especially one-celled microorganisms, can change form under certain conditions to cells of another type. They contended that no matter where germs came from they presented a danger only if the body was in a run-down state due to a disturbed "milieu interieur". Pasture and his friend, Koch, were more vocal, won the argument and swayed the world into believing that the postulates of Koch and germ theory were correct.
Thus as the 19th Century came to a close, two schools of thought about disease and health existed: pleomorphism as espoused by Bechamp, Enderlein and Ernst Almquist (1852-1946) of Sweden, and monomorphism as propounded by Pasteur and Robert Koch (1843-1910) of Germany. Cowan: Pleomorphism
Pasteurian Germ Theory vs. Bechamp Cellular Theory
As described by Walene James: James: germs
|
Germ Theory (Pasteur) |
Cellular Theory (Bechamp) |
| 1. Diseases arise from micro-organisms outside the body. | Disease arises from micro-organisms within the body. |
| 2. Micro-organisms are generally to be guarded against. | These intracellular micro-organisms normally function to build and assist in the metabolic processes of the body. |
| 3. The function of micro-organisms is constant. | The function of these organisms changes to assist in the catabolic (disintegration) processes of the host organism when that organism dies or is injured, which may be chemical as well as mechanical. |
| 4. The shapes and colours of micro-organisms are constant. | Micro-organisms change their shapes and colours to reflect the medium |
| 5. Every disease is associated with a particular micro-organism. | Every disease is associated with a particular condition. |
| 6. Micro-organisms are primary causal agents. Micro-organisms become "pathogenic" as the health of the host organism deteriorates. |
Hence, the condition of the host organism is the primary causal agent. |
| 7. Disease can “strike” anybody. | Disease is built by unhealthy conditions. |
| 8. To prevent disease we have to “build defenses.” | To prevent disease we have to create health. I would also add to reverse disease, we have to create health. |
 Since that early era, many astute scientists and doctors [ Enderlein, Rife, Reich, Livingston-Wheeler,
Naessens, and more recently, in the U.S., Dr. Robert O. Young (San Diego) and Dr. David Jubb (New York) ] over the past 100 years have challenged the monomorphism theory and the
medical practice of today.
Donohoe: Medical error
Since that early era, many astute scientists and doctors [ Enderlein, Rife, Reich, Livingston-Wheeler,
Naessens, and more recently, in the U.S., Dr. Robert O. Young (San Diego) and Dr. David Jubb (New York) ] over the past 100 years have challenged the monomorphism theory and the
medical practice of today.
Donohoe: Medical error
The differences in the two theories, monomorphism and pleomorphism, came about from the techniques of using microscopes and preparation of specimens. [ although this most critical aspect was overlooked in the arguments ]. The early low magnification microscopes of Pasture and other researchers at the turn of the century had a maximum magnification of 1000 and stained the blood culture samples. Staining dyes killed all living blood organisms. On the other hand, the new microscopes of Rife, Livingstone, Naessens and others had a magnification of 20,000 to 30,000 and did not stain the blood samples. The low magnification microscopes can not display organisms smaller than viruses and in living color, whereas the microscopes of Rife, Livingstone and Naessen were able to display the smallest organisms alive and moving about. [ All three scientists had their work disrupted and suppressed by the FDA. ]
Pleomorphism: Béchamp was able to prove that all animal and plant cells contain tiny particles which continue to live after the death of the organism and out of which microorganisms can develop. In his book Mycrozymas, Béchamp laid the foundation for the concept of pleomorphism. Bechamp:where protits come from
Whenever there is anything in nature that is dying, beginning to decay, something comes and eats it up. In this case the internal environment of the cells change [ from living to dead cells ], triggering the protits to change into the microbes [ that come out of the tissue cells ] to clean up any toxins or decaying stuff found in the body. That is what microbes, germs, are for. According to Béchamp, germs are the result, not the cause of disease!
These tiny organisms, referred to as protits by Enderlein,are what come from the air and get in water, wine or whatever and do what they are supposed to do, eat sugar. These protits are everywhere, in the air, the ground, in all living things, plants, animals. In wine they turn into the yeast cells that do what they have to do, eat it, ferment it.
What are Protits [ Enderlein ], Microzymas [ Béchamp ], Naessens [ Somatids ]?
 Sizes of bacterium, virus and protits; not drawn to scale. Courtesy Walter Sorochan
|
The small white dots the arrow is pointing to are the Protits. The large empty dark circles are red blood cells. Courtesy Naessens |
Protits are tiny dot forms. These forms are the end and the beginning of all physical life. All cells, organs, and living forms are built from these 'little bodies'. Protits continue to live after the death of the organism and out of which microorganisms can develop. Bechamp:where protits come from
Theory of Protits
Protits are also ubiquitous. That is, everyone carries them, both in sickness and in health. Bechamp:where protits come from
More scientific proof that protits exist can be found in observing the aging of a blood smear slide over one to two days. Organisms literally can be seen [ in a high powered microscope ] wiggling out of the red blood cells, organisms that change into more degenerate and pathological forms as the process proceeds. When the rotting or putrefaction process is over, when there is nothing more for the newly formed viruses, bacteria and fungi to eat, they all break apart again, disappear, and turn back into the "little dots" they came from, that is, into Protits/Microzymas/Somatids. They eat themselves and are reborn, [ Reference to mythogy reports of the alchemical snake forever eating its tail (the Uroboros) or the Phoenix, a mythical bird of great beauty that was reborn from the ashes of its own funeral pyre. ]
Video of protits by Naessens: ALERT: [ You may need to install a free version of ActiveX on your computer, to view videos. ]
Naessans Earth's Tiniest Living Organisms: Somatids
Protits are the dark dots visible on a [ unstained ] blood slide when viewed under high magnification with special microscopes. Profits never die! All animal and plant cells contain these tiny particles which continue to live after the death of the organism and out of which microorganisms can develop. When anything in nature is dying, it is the protits that begin decay, protits come and eat it up.
What triggers protits to change form? It is the internal environment or “terrain” of a plant, animal or human. In humans, terrain is a change in the blood pH from a slightly alkali 7.3 to an acid pH less than 7.
Is there any scientific evidence that protits never die? Scientists have discovered that chalk and limestone are composed of protits. When limestone is placed in water, one can observe fermentation and tiny objects start moving and rolling. A similar fermentation action is observed when mummies in Egypt are put in water. Protits just start eating sugar again, fermenting their environment depending on acid - base condition, after thousands or millions of years. It never stops, Life. Bechamp:where protits come from
Additional observations of protits:
"After slow thawing, protits isolated from a mammoth frozen more than 50,000 years ago were shown to spontaneously show life again and begin fermentation in sugar solutions."
The following is from SANUM-TherapieBetrachtungen und Erfahrungen Eine Heilbehandlung an der Basis von Wilhelm Fries;
"the Russian researcher Ginsberg-Karagitschewa provided proof in 1926 that protits isolated from petroleum showed complete viability and started the fermentation of sugar. A German by the name of Shwartz confirmed this also for German petroleum."
Both private instructor E. Santo and H. P. Rusch were able to find the same results, namely the isolation of living Protits from German hard coal. The researches of Santo and Rusch also showed that the Protit could not be harmed by sulfuric acid or by temperatures of 1300°C in a ceramics oven.
In addition, Wilhelm Friez also states that the above researchers and Enderlein, on suitable nourishing media, were able to grow viable bacteria from the protits isolated from the coal and oil. Streptococci, coliform bacteria and Proteus species were all isolated from these substances." Bechamp:where protitscome
Health vs Disease: Now lets take another look at pleomorphism. Donohoe: Medical error
"We are constantly breathing in some 14,000 germs and bacteria per hour. If germs are so harmful, why aren't we all dead?" Microzymas
Protit, an independently living microform, exists within all living things, and is both the builder and recycler of organisms. In a state of health, the protits act harmoniously and fermentation occurs normally, beneficially. But in the condition of disease, protits become disturbed and change their form and function. They evolve into microscopic forms (germs) that reflect the disease and produce the symptoms, becoming what Béchamp called "morbidly evolved" microzymas. Microzymas |
Béchamp and other scientists Cantwell: blood bacteria | Naessens believed in the theory of pleomorphism, that a microbe could evolve through many forms from virus to bacterium to yeast to fungus to mold and could even de-evolve back to a pre-virus again. Béchamp could see this evolution and de-evolution clearly in his microscope. The Medical Establishment has rejected pleomorphism and has continued to reject these “real time” observations.
Another of Béchamp's contemporaries, Claude Bernard, expounded on the pleomorphic theory and said that the inner terrain or "milieu interieur" was the cause of disease, and not microbes. It was discovered that acidic blood and tissue provide an internal environment [ terrain ] that is ideal for disease to develop. When the terrain becomes acidic, microbes evolve into pathogenic forms and carry out the work nature designed them to do – as cleaners and undertakers, scavenging inflamed or infected tissue.
"A healthy or diseased biological terrain is determined primarily by four things: its acid/alkaline balance (pH); its electric/magnetic charge (negative or positive); its level of poisoning (toxicity); and its nutritional status." Microzymas
The acidity or acid/alkaline balance of the blood is measured by pH and is a very important marker for good health. The blood will do all it can to keep its pH at 7.365, or slightly alkaline. It will even strip alkaline reserves like calcium from the bones to buffer a rise in acidity. [ This can lead to a condition labeled by modern medicine as osteoporosis. ] When the pH drops, even by 00.1, the increase in acidity is interpreted by the protit microbes [ already present in the body in their billions ] as a sign of a a body in trouble, dead or dying body. This prompts them to morph from benign bacteria into virulent yeast and mold so that they can decompose the dead body.
Under this perfect condition of a pH = 7.3, the microzyma, or the protit as Enderlein called them, live in perfect harmony with the body. However, when the pH increases (more alkalic) or decreases (more acidic), the protits can not survive and transform into another pleomorphic shape.
So, the pH of the blood is the most important factor to determine the state of the microorganisms in the blood. Another important factor is the mineral and vitamin status in the blood, and as will become clear this is quite complex as both factors are related. Diet is the most important factor to control the pH. Getting an alkali body For more information about new information about health go to: Health Menu
Immunity and Protits:
Protits, named by Naessens as somatids or super small particles, can be cultured outside the bodies of the host. Naessens also observed that the tiny particle had a pleomorphic (form-changing) life cycle, and had a sixteen-stage life cycle. Only the first three stages of the somatid life cycle are normal.
Naessens discovered that when the immune system is weakened or disrupted, the somatids [ protits ] go through the other thirteen stages. Naessens The weakening of the immune system could be brought about by a number of factors such as exposure to chemical pollution, ionizing radiation, electric fields, poor nutrition, accidents, shock, depression, and many more factors. The ability to culture somatids is a bellwether to the rewriting of microbiology!
"Seventy percent of your immune system resides in your small intestine due to the presence of “friendly” bacteria." [ Elizabeth Lipski (2004). Text: Digestive Wellness. P. 27. ]

Courtesy Naessens
Elswick: Story Naessens
Videos: Videos Cantwell ALERT: You may need to install a free version of ActiveX on your computer, to view videos
Here are two videos about protits and pleomorphism. Viewed with Ergonom 500 microscope, you can see living viruses (endbionts) in action transforming into bacteria and fungal forms.
Video 1 Alan Cantwell Alan Cantwell The cancer microbe & the Russell bodies
A NEW Health Model:
The pleomorphic theory and protits give us a new way of looking at health: Maintaining the body environment in an alkali pH! How do we do this? The answer to this is based on documented research that focuses on our life style and eating habits.
The foods we eat determine the blood and body pH. The wrong food can evolve an acid pH that, in turn, evolves excessive amounts of unstable superoxides. These superoxide's stabilize and become free radicals that are poisonous to our body. Our body does have the mechanisms to get rid of free radicals. When free radicals overwhelm the body, the immune system is compromised and we acquire autoimmune, degenerative diseases and disorders.
The body attempts to maintain a healthy body by removing free radicals from the body. This is done by antioxidants that neutralize the free radicals.
Unfortunately, humans lose most of their ability to provide primary antioxidants or superoxide dismutase or SOD early in life. We can compensate for this innate loss by eating fresh fruits, vegetables and flax seeds rich in certain antioxidants. Choosing foods according to whether they are acid forming or alkali forming can have a major impact on one's ability to heal and maintain health.
But food antioxidants provide a very small amount of needed antioxidants. Additional help in making the body more alkali is to eat less meat. But these eating attempts to provide more antioxidants to minimize free radicals is miniscule to the amount needed. Our bodies survive in a deficit!
We need orthobiosis, or the right and proper style of life, to attain and maintain adequate health and minimize the risks of disease and disability! Although we lack good supplements to provide the proper amount of antioxidants that our bodies need, we need more and better research to help us do so.
Where do we go from here?
The conflict between Pasteur’s germ theory [ monomorphism ] and Bechamp’s cellular theory [ pleomorphism ] must be resolved. This is already an issue that is happening with orthodox or conventional vs. unconventional medicine today. The conventional health and medical systems in the world today are not working very well. France hea care in trouble | Gawende: Obama reform & other systems | Problems with Socialized Health Care
The political stranglehold on the practice of medicine by vested corporations needs to be reviewed and changed.
"This New Biology is about re-uniting these so-called different forms of medicine and re-integrating them. It is about finding the common denominators, the biases that are the common causes of disease. ... These isolated bits of 'specialized' knowledge just need to be reunited." Myers: Monomorphism
The contributions of both medical theories and models need to be recognized and molded into a working model of comprehensive health care. Both models should work to improve health and minimize the cost of health care. Sick persons should have a choice in their therapy. With these new concepts in mind, the medical curriculae in Medical Schools needs to be changed immediately.
"The 100 year old model of medical education based on the Flexner Report needs updating. As the practice of medicine changes, the educational needs of physicians have changed." [ wikipedia: Medical school in USA ]
No one should be allowed to make money on sick or disabled people. Governments must provide an equal playing field for both models, supportive legislation, motivation and reinforcements for preventing illness and diseases and promoting optimal well-being. These ideas should be the crux of health care reform!
Politics of medicine: Modern medicine has disappointed most people. People and their governments have invested billions of dollars with very little to show in terms of better health and less economic cost. That health care systems in most countries are not working [ US hea care in crisis | US insurance crisis | Greece and Financial debt France hea care in trouble ] is an opportunity for change and improving the current health care system.
The nature of the health care system aside, the real health problems are not medical doctors, health care providers or hospitals, but instead, the behaviors of people --- their lack of self discipline to exercise and eat properly. The majority of people have bad behaviors and habits and lack the acumen to make wise choices. Our American culture has spawned a disease culture.
Health care leadership and reinforcements must come from the government to prevent illnesses, diseases and disorders that are inflicted by an out of control and broken free enterprise system. We must start inculcating attitudes and evolving good health habits early in kindergarten and provide continuous reinforcements for orthobiosis [ proper style of living ]. This alone is the health care reform that has the potential to reduce health care costs, create a more efficient health care system and improve the quality of life more than other reforms!
|
**Give a hungry man a fish and
"But give him a fishing pole and he will feed himself the rest of his life!" |
Frustration can be seen in the faces of people who view the political spin put on health and political advertisements. People are confused about what and who to believe! But such disappointment has opened the doors for reforming the health care system. Unfortunately, the current health care system is under economic-political lock with the drug and insurance corporations and the federal government holding the key to better health care opportunities. This makes it difficult to bring about change. Reforming health care
There is strong opposition to accepting the pleomorphic theory.
It has been said, "Doctors fear drug companies like bookies fear the mob."
Sharav: conflicts of interest
Physicians, schooled in the germ theory in medical schools, are reluctant to accept that the same type of "tiny microbe" present in a healthy individual could cause a variety of chronic diseases in the same person. Embracing such a new belief of medicine would jeopardize their license to practice medicine.
Change is painful, confusing, expensive and there may not be a best way of bringing about change. Surely an eclectic health care system, that compromises and allows both systems to be a public right of choice, would be a best fit for everyone.
Medical change and reform is knocking on everyone’ s door. All we have to do is open the door! The world is what we make it!
References:
Barron Jon, "World's Greatest Medical Failures," Baseline of Health Foundation, July 21, 2008. Barron: Med failures
Bechamp Antoine, Antoine Bechamp," Where do protits come from? Bechamp:where protits come from
"Chalk, limestone, is composed of the Protits of the bacteria which living beings of the geological epochs had become and these materials will start sugar water fermenting. The mummies in Egypt are composed only of left over Protits which do the same, start fermentation. Put these back in water, the mummies or the chalk, and their "little dots" start rolling, moving once again. They just start eating again, fermenting their environment debending on acid base, after thousands or millions years. It never stops, Life.
From Viennese Medical Week, No. 34; "After slow thawing, Protits isolated from a mammoth frozen more than 50,000 years ago were shown to spontaneously show life again and begin fermentation in sugar solutions."
The following is from SANUM-TherapieBetrachtungen und Erfahrungen Eine Heilbehandlung an der Basis von Wilhelm Fries; "the Russian researcher Ginsberg-Karagitschewa provided proof in 1926 that Protits isolated from petroleum showed complete viability and started the fermentation of sugar. A German by the name of Shwartz confirmed this also for German petroleum."
Both private instructor E. Santo and H. P. Rusch were able to find the same results, namely the isolation of living Protits from German hard coal. The researches of Santo and Rusch also showed that the Protit could not be harmed by sulfuric acid or by temperatures of 1300°C in a ceramics oven.
In addition, Wilhelm Friez also states that the above researchers and Enderlein, on suitable nourishing media, were able to grow viable bacteria from the Protits isolated from the coal and oil. Streptococci, coliform bacteria and Proteus species were all isolated from these substances.
The form of the bacteria isolated by doing the above,"on suitable nourishing media", depends on the nourishing-growth media the Protits are grown on. How acid that growth media is, what it is made of, how much oxygen, the rH-oxidation/reduction factor, lots of things effect this. It is the same in the living body, the internal milieu, the environment the Protits grow in, determines what form the Protits take, i.e. whether they are good guys or not so good.
This is the Law of Conservation of Energy. Life energy too does not just come from nothing with birth and then disappear into nothing with death. It too is conserved.
These Protits are what come form the air and get in sugar water, wine or whatever and do what they are supposed to do, eat. These Protits are everywhere, in the air, the ground, in all living things, plants, animals...In wine they turn into the yeast cells that do what they have to do, eat it, ferment it."
Beck Andrew H. “The Flexner Report and the Standardization of American Medical Education,” JAMA. 2004;291:2139-2140. Beck: Flexener Report
British staff writer, "British NHS facing financial crisis," Washington Times, March 3, 2005. British: financial crisis
Broxmeyer Lawrence, MD “Heart Disease - Beyond The Stent & Bypass Cardiac Coverup,” rense.com, 2009. Broxmeyer: Heart disease
Campaign Against Fraudulent Medical Research Fraudulent Medical Research
Cantwell, Alan, "All Human Blood Is Infected With Bacteria," Cantwell: blood bacteria
Cantwell Alan, "Pleomorphic Bacteria as a Cause of Hodgkin’s Disease (Hodgkin’s lymphoma): A Review of the Literature, JOIMR 2006;4(1):1 Published: 21 February 2006. Article no longer available.
Cowan Dave, November 16, 2003 Cowan: Pleomorphism | Cowan: Pleomorphism 2
Domingue Gerald J. et la., “Novel baterial structures in human blood: cultural isolation,“ Inceftion and Immunity, February, 1977, pp 621-627. Dominique: Immunity
Donohoe Gabriel, “Is Modern Medicine Founded on Error?” Natural News.com, December 07, 2007. Donohoe: Medical error
Eisen Jonathan, "Suppressed inventions and other discoveries," Eisen: suppressed invetions
Elswick Steven R., “ Theamazing story of Steven Naessens,” Nexus Magazine, February--March 1994. Elswick: Story Naessens
EutoAmerican3, "LIFE - Darwin or Creationism," EAM: Life
"The protit of Enderlein has been called the Colloid of Life. These protits are particles that measure .01 to .0001 microns in diameter (that is about four hundred thousandths to four millionths of an inch.) The average red blood cell on the other hand is about 7 microns in diameter.
The following two Latin statements constitute the Cell Theory of Biology which is the most basic principle of Biology and which is on the first page of any Biology text book.
Omne vivum ex vivo - All life comes from previous life.
Omnis cellula e cellula - Every cell arises from subdivision of preexisting cells.
The above are dictums from the church, not science. The purpose of this chapter will be to unite the apparently divergent view of the church (Creationism) and science (evolution).
The first individual to actually catch a glimpse of the occurrence of cells apparently coming out of nowhere and therefore not requiring subdivision of preexisting cells was Anton Leeuwenhoek who lived in the 17th century. He had ground glass to create the first microscope. In observing some rainwater he collected, he made note that there were tiny creatures moving about. Wondering where they came from, he did an experiment. He collected clean fresh rainwater and sealed it in pipettes. At first, nothing was in the water. Hours and a few days later, still nothing was in the water. However, on the fourth day, all of a sudden, little tiny creatures (protits) appeared. Where did they come from? Was it spontaneous generation?
"All organisms, and all of the cells that constitute them, are believed to have descended from a common ancestor cell through evolution by natural selection."
Frazier Wade, "Medical Racket," Frazier: Medical Racket Frazier: War on quacks
Gawande Atul, "Getting There from Here How should Obama reform health care? The New Yorker, January 26, 2009. Gawende: Obama reform & other systems
Getting Sick & diseases Article no longer available.
Higdon Jane and Victoria J. Drake, "Lignans," Linus Pauling Institute, Oregon State University. [Flaxseeds are the richest dietary source of lignan precursors The richest source of lignans is flaxseed, containing more than 100 times the amount found in other foods! But flax seed oil does not contain lignans.] Artilce no longer available.
|
Total Lignan Content of Selected Foods
|
||
| Food | Serving |
Total Lignans (mg)
|
| Flaxseeds | 1 oz |
85.5
|
| Sesame seeds | 1 oz |
11.2
|
| Curly kale | ½ cup, chopped |
0.8
|
| Broccoli | ½ cup, chopped |
0.6
|
| Apricots | ½ cup, sliced |
0.4
|
| Cabbage | ½ cup, chopped |
0.3
|
| Brussels sprouts | ½ cup, chopped |
0.3
|
| Strawberries | ½ cup |
0.2
|
| Tofu | ¼ block (4 oz) |
0.2
|
| Dark rye bread | 1 slice |
0.1
|
Hirneise Lothar, “Cancer survivors,” Hireise: cancer survivors
Hirneise Lothar, “How stress causes cancer at the cellular level,” Hireise: cancer cause
James Walene, James: germs
Lignans: and antioxidants foods rich in antioxidants
Livingston Virginia, Livingstone
McCreery Andrea, “What is Pleomorphism?’ Rocklin and Roseville Today, October 08, 2006. McCreery: Pleomorphism McCreery: Pleomorphism2
Naessens Naessens The research of Gaston Naessens has culminated in the discovery of 714X — an enzyme which helps the immune system to do its job. 714X is a derivative of camphor.
Pasture a fraud, Pasture a fraud
Pearson R.B., "Pasteur, Plagarist, Imposter" The Dream and Lie of Louis Pasteur
Raging debate:, "Alternative Approaches to Cancer Therapy,"
Pleomorphism has already been proved to exist in all microbial forms throughout the last hundred years by various distinguished research from Prof. Antoine Bechamp, Gunter Enderlein, Royal Rife, Gaston Naessens, Virginia Livingston and Tullio Simoncini. As far back as 1914, a microbiologist named Ms Marie Henri proved that pleomorphism existed in her Anthrax bacterium studies and her evidence was even presented at the Pasteur Institute in Paris. She even admitted that through this discovery, Pasteur's Germ Theory must be wrong.
Rense Jeff, “Royal Raymond Rife,” Rense: Rife
Reuters, "French government to tackle surging health care deficit," Sep 7, 2009. France hea care in trouble
Socialized Health Care Systems, "The Problems with Socialized Health Care," Article no longer available.
Theory of Microzymas. Microzymas
"In the 3rd Edition, Basic Histology, Junqueira & Carneiro, 1980, we discover the limitations of the electron microscope in that the electron beam demands the use of very thin tissue sections enclosed in a high vacuum. The authors of these requisites state on page 9: "These conditions preclude the use of living material...and...The electron beam on an object can damage it and produce unwanted changes in tissue structures. They take a living, changing scene (the blood), and disorganize it, by staining the blood sample. They then take a snapshot of this disorganized situation and interpret it as the entire story."
Wikipedia, “Flexenir Report,” Wiki: Flexenir Report